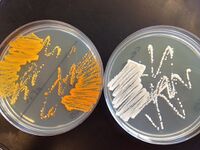
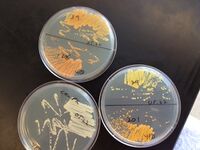

User:Nkuldell/VitaYeast
VitaYeast
From Boeke lab at Johns Hopkins, iGEM 2011 project
Data page is here [1]
2007 paper describing Carotenoid production in S. cerevisiae is:
Appl Environ Microbiol. 2007 Jul;73(13):4342-50. Epub 2007 May 11.
High-level production of beta-carotene in Saccharomyces cerevisiae by successive transformation with carotenogenic genes from Xanthophyllomyces dendrorhous.
Verwaal R, Wang J, Meijnen JP, Visser H, Sandmann G, van den Berg JA, van Ooyen AJ.
Source
Fungal Genomics, Laboratory of Microbiology, Wageningen University, Dreijenlaan 2, Wageningen, The Netherlands. pdf here
Initial communication about strains with Leslie Mitchell in Jef's lab
The authors supposedly sent us the four strains shown in Figure 4. I got a copy of these four strains from one of the iGEM-ers when I arrived in the lab - they were labelled 039, 128, 179, and 201. I can't figure out where these names came from and he wasn't too sure either, but I have continued to use the names. When the strains arrive in your lab I will use these labels as well.
In any case, I can give you the following information (this will make more sense once you read through the methods of the paper):
The four strains in Figure 4 should have the following genotypes:
- crtYB/I/E at URA3 - should be URA+ leu- trp-
- crtYB/I/E at URA3; Extra crtI at LEU2 - should be URA+ LEU+ trp-
- crtYB/I/E at URA3; tHMG1 at TRP - should be URA+ leu- TRP+
- crtYB/I/E at URA3; Extra crtI at LEU2; tHMG1 at TRP - should be URA+ LEU+ TRP+
in reality the 4 strains in our lab have the following genotypes:
- 179: URA+ LEU+ trp-
- 128: URA+ leu- TRP+
- 201: URA+ LEU+ TRP+
- 039: URA+ LEU+ TRP+
So clearly something doesn't quite jive between what is in the figure and the genotypes of the strains we have in the lab. But in any case, we do know for sure that all 4 strains do indeed contain at least one copy of crtYB/I/E - they all PCR amplify using primers specific for these genes. I've also attached a figure with the colours of the four strains compared to CEN.PK.
Cheers,
Leslie

Note: CEN.PK strain is described here
NOTE: there seems to be a mix up between 128 and 179 from the picture above and what I streaked out in the MIT lab. Strain "128" is the one that's more orange than yellow and that gives off white, yellow and red colonies and that's trp-. This strain was stored in my lab collection as NY458.
Getting started
- From Leslie:
- Filter paper method - I just cut up filter paper into little squares, wrap them individually in tin foil, then autoclave.
- When I want to send a strain, I resuspend a big scoop of cells in a small volume of media or water so I have a really dense 'culture', then spot ~50 uL onto the filter paper. re-wrap and send.
- To wake it a strain, I would dump the inoculated filter paper onto the appropriate plate, move it around a little with a sterile stick, and then streak for isolates using the stick. I usually repackage the filter paper in the tin foil just in case something goes wrong with the plate.
- Works like a charm for yeast and bacteria. I imagine either type of cell would be fine for several days, maybe a week, before streaking on media, but I have never done that experiment.
Summer 2012 Experiments
Primers
CrtYB
- Genomic CrtYB seq from X. dendrorhous is here
- also part # BBa_K530000 available in NB480 (CamR)
- Pr-crtYB-Tr-F
- NO298
- AAAACTGCAGCAGTTCGAGTTTATCATTATCAAT
- Pr-crtYB-Tr-R
- NO299
- TTTTCTGCAGGCGGCCGCGCAAATTAAAGCCTTCGAGCG
- crtYB-ORF-F
- NO302
- 5'- ATG ACG GCT CTC GCA TAT TAC CAG ATC CAT CTG ATC TAT ACT CTC CC -3'
- crtYB-ORF-R
- NO303
- 5'- TTA CTG CCC TTC CCA TCC GCT CAT GAC CAC ACT CAA GAC TTT CCG TAC -3'
CrtE
- Genomic CrtE seq from X. dendrorhous is here
- also part # BBa_K530001 available in NB481 (CamR)
- crtE-ORF-F
- atggattacgcgaacatcctcacagcaattccactcgagtttac (made longer than published oligo to help with PCR amplification from dirty template)
- NO306
- crtE-ORF-R
- TCA CAG AGG GAT ATC GGC TAG CTT TTT CAG GAT CGC TTC CAA TTT GAC G (made longer than published oligo to help with PCR amplification from dirty template)
- NO307
CrtI
- Genomic CrtI seq from X. dendrorhous is here
- also part # BBa_K530002 available in NB482 (CamR)
- Pr-crtI-Tr-F
- NO300
- CGGGGTACCCAGTTCGAGTTTATCATTATCAAT
- Pr-crtI-Tr-R
- NO301
- GCCGGTACCGGCCGGCCGCAAATTAAAGCCTTCGAGCG
- crtI-ORF-F (made longer than in paper to improve confidence in PCR amplification from dirty template)
- atgggaaaagaacaagatcaggataaacccacagctatcat
- NO308
- crtI-ORF-R
- TCA GAA AGC AAG AAC ACC AAC GGA TCG AGC GAT CAC GGC CCC AAT ((made longer than in paper to improve confidence in PCR amplification from dirty template)
- NO309